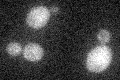
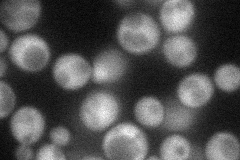

View description
Calpain-like cysteine protease involved in proteolytic activation of Rim101p in response to alkaline pH; has similarity to A. nidulans palB
Localization:
Intensity:
Fold change:
Significance:
-
C’ GFP library in SD
below threshold15.73 -
N' NOP1pr-GFP in SD
cytosol49.1741 -
N' TEF2pr-mCherry in SD

cytosol49.2594 -
N' NATIVEpr-GFP in SD

cytosol19.9153 -
N' TEF2pr-VC and Cyto-VN in SD

cytosol33.4926 -
C’ GFP library in SD+DTT

cytosol17.521.11No -
C’ GFP library in SD+H2O2

cytosol16.981.07No -
C’ GFP library in Starvation Media

cytosol14.440.91No -
C’ GFP library on the background of Pup2-DaMP

below threshold -
C’ GFP library on the background of CCT mutant

below threshold18.66731.18616No
